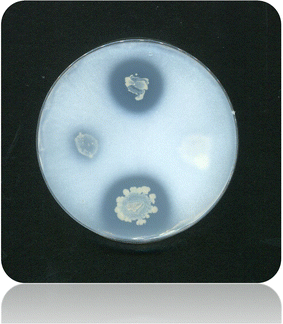

- Article
- Published:
Isolation and characterization of rhizomicrobial isolates for phosphate solubilization and indole acetic acid production
Journal of the Korean Society for Applied Biological Chemistry volume 58, pages 847–855 (2015)
Abstract
Recently, public concerns regarding the use of agrochemicals have increased due to the environmental impacts and potential risks to human health. The application of beneficial microorganisms is a novel technology to improve plant health and productivity and has therefore been extensively studied as an alternative strategy for biocontrol. In our study, 122 microbial isolates were obtained from the rhizosphere of Panax ginseng and subsequently tested in vitro for phosphate solubilization and indole acetic acid (IAA) production. Pikovskaya’s medium was used to estimate rhizomicrobial isolates to solubilize tricalcium phosphate [Ca3 (PO4)2]. Among all the investigated strains, 82 % of rhizospheric fungi showed phosphate solubilization activity; however, only 57.1 % of the rhizobacteria isolates showed phosphate solubilization ability. For IAA production, 64.7 % of the tested rhizofungi isolates were able to produce the phytohormone; however, only 47.62 % of the rhizobacteria isolates exhibited IAA production. Among all investigated species, Pseudomonas fluorescence and Azotobacter chroococcum showed the highest phosphate solubility demonstrating 885.4 and 863.4 μg mL−1, respectively. Mucor sp. produced 42.3 μg mL−1 of IAA in Czapek’s tryptophan medium, and the highest fungal species to solubilize the inorganic phosphate (237.5 μg mL−1) was estimated by Penicillium sp. Rhizobacteria were more effective than rhizofungi in phosphate solubilization and IAA production. This study introduces some potent species in terms of phosphate solubilization and IAA production which could be likely to improve soils’ quality and promote plant growth.
Introduction
Root-associated bacteria and fungi have been known to benefit plants and are therefore referred to as plant growth-promoting rhizobacteria (PGPR) and plant growth-promoting fungi (PGPF), respectively (Kloepper et al. 1990; Reyes et al. 2002). The PGPR are organisms that possess some direct mechanisms to enhance plant growth (Kloepper et al. 1989). Biogeochemical cycles are important features of soil bacteria that provide plants with sources of nutrition and therefore improve crop production. Indigenous microflora is superior to improve crop performance due to traits pre-adapted to the local environment relative to introduced strains. A number of various bacteria enhance plant growth, including Azotobacter sp., Pseudomonas sp., Bacillus sp., and Acetobacter sp. (Turan et al. 2006). Microorganisms with phosphate-solubilizing capacity increase available phosphate and improve plant growth (Ponmurugan and Gopi 2006). Goldstein (1994) reported that soluble phosphate concentration in soil is often very limited approximately 1 μg mL−1 or less. The capacity of microbes to release metabolites, including organic acids, determines phosphorus-solubilizing activity, which converts phosphorus to soluble forms (Sagoe et al. 1998). Large numbers of saprophytic bacteria and fungi solubilize phosphorus in scarcely soluble soil phosphates, mainly by chelation-mediated mechanisms (Whitelaw 2000). Phosphate-solubilizing bacteria enhanced Cicer arietinum seedling growth (Sharma et al. 2007). Moreover, co-inoculation of phosphate-solubilizing microorganisms and plant growth-promoting rhizobacteria reduced the application of phosphate by 50 % without affecting corn yield (Yazdani et al. 2009). Phosphate solubilization takes place via different microbial actions, including organic acid production and proton extrusion (Surange et al. 1995; Dutton and Evans 1996). Microorganisms increase the phosphate available to plants by mineralizing organic phosphates in soil and by solubilizing precipitated phosphates (Pradhan and Sukla 2005; Chen et al. 2006). Various bacteria and fungi are known to solubilize phosphates and increase plant yield. Phosphate-solubilizing microorganisms in soil solubilize insoluble phosphates, mainly by secreting organic acids, which chelate with calcium ions lowering the pH (Arti and Patel 2003). Strains from the bacterial genera Pseudomonas and Bacillus, as well as the fungal genera Penicillium and Aspergillus, are the most effective phosphate solubilizers (Whitelaw 2000). Chen et al. (2006) reported that Arthrobacter ureafaciens, Phyllobacterium myrsinacearum, Rhodococcus erythropolis, and Delftia sp. have the capacity to solubilize considerable amounts of tricalcium phosphate in the medium by organic acid secretion. Rhizomicroorganisms solubilize phosphorus and produce phytohormones, which are essential for enhancing crop productivity. Biosynthesis and phytohormone release of indole acetic acid (IAA) is an additional important PGPR mechanism, which enhances plant growth (Seshadri et al. 2002). It was hypothesized that plant growth was regulated by ‘a substance, which transmits its effects from one part of the plant to another’ (Kevin 2003). Later, this ‘substance’ was termed auxin (‘auxein’ in Greek means ‘to grow’), and auxins were identified as IAA (Kevin 2003; Spaepen et al. 2007). One of the most important traits identified in plant growth-promoting microorganisms (PGPM) was the capacity to produce phytohormones (Husen 2003). Therefore, many studies examined the production of the phytohormone IAA in phosphate-solubilizing fungi. Either symbiotic or non-symbiotic PGPR, which act on the production of plant hormones, including auxins and gibberellins, promote plant growth directly. Hayat et al. (2010) reported that several bacterial genera produced indole-3-ethanol or indole-3-acetic acid (IAA), compounds belonging to auxins, and the results indicated that not only plants but also microorganisms, including bacteria and fungi, synthesize IAA (Kevin 2003). Plant growth can be directly enhanced via phytohormone synthesis (Xie et al. 1996), as well as the solubilization of inorganic phosphate and mineralization of organic phosphate, which makes phosphorous available to plants (Khan et al. 2014). Previous studies (e.g., Hontzeas et al. 2004) demonstrated that PGPF performed one or several mechanisms to promote plant growth, including phytohormone production, mineral solubilization, and antagonism, toward phytopathogens. The aim of the present work was to evaluate phytohormone biosynthesis and phosphate solubilization in indigenous bacteria and fungi isolated from the rhizosphere of Panax ginseng (Korean ginseng) and to select promising strains for future experiments to determine strain efficacy as plant growth-promoting rhizomicrobes.
Materials and methods
Bacterial and fungal isolates
A total of 105 bacterial isolates and 17 fungal isolates were taken from the rhizospheric soil supporting P. ginseng. All strains were purified and screened to examine plant growth promotion PGPR traits of inorganic phosphate solubilization and IAA productivity.
Isolation of rhizobacteria
Rhizosphere soils were collected from P. ginseng (Korean ginseng) fields. Plants were uprooted, placed in zipper bags, and transported to the laboratory. Non-rhizosphere soil from ginseng plants was removed by gentle root shaking, and the soil tightly adhering to the roots (rhizosphere soil) was separated. Dilution plate method was applied for isolation under aseptic conditions, and trypticase soy agar was used to culture bacteria (Atlas 2004). Additional streaking on fresh plates was performed to selected colonies. Fungi were isolated on Czapek’s solution agar containing 30 g saccharose, 2 g sodium nitrate, 1 g dipotassium phosphate, 0.5 g magnesium sulfate, 0.5 g potassium chloride, 0.01 g ferrous sulfate, and 15 g agar. Additional isolate purification and multiplication was conducted by streaking on 2 % malt extract agar plates grown at 27 °C and stored at 5 °C prior to further screening.
Rhizosphere isolates identification
Fungal strains were identified by direct microscopic examination, and culture features were identified according to Domsch et al. (1980) and Moubasher (1993). Bacterial colonies with different characters were tested biochemically and identified using the Bergey’s manual of systematic Bacteriology (Holt 1986). Moreover, in order to confirm the identification, the 16S rDNA of some strains was amplified with the 16F27 (forward) (5′-AGAGTTTGATCCTGGCTCAG-3′) and 16R1542 (reverse) (5′-AAGGAGGTGATCCAGCCGCA-3′) universal primers according to Gürtler and Stanisich (1996). The partial 16S rRNA gene sequence was compared with the full sequence available in the GenBank database using a BLAST search to identify the isolated bacteria.
Phosphate-solubilizing activity
Tricalcium phosphate [Ca3 (PO4)2] was considered a model compound for measuring the potential or relative rates of microbial solubilization. Precipitated [Ca3(PO4)2] solubilization on Pikovskaya’s agar medium (g L−1; yeast extract 0.5, dextrose 10, calcium phosphate 5, ammonium sulfate 0.5, potassium chloride 0.2, magnesium sulfate 0.1, manganese sulfate 0.0001, ferrous sulfate 0.0001, agar 15) was used for isolation of phosphate-solubilizing microorganisms (Pikovskaya 1948). Rhizosphere microorganisms on precipitated calcium phosphate agar produced clear zones around colonies if colonies were capable of solubilizing calcium phosphate. Phosphate solubilization was estimated quantitatively by an inoculating loop full of spore suspension isolates in 10 mL of Pikovskaya’s broth at an initial pH adjusted to 7.0; bacteria were incubated at 30 °C for 3 days and fungi at 27 °C for 7 days. Ion Chromatography was used to analyze the soluble inorganic phosphorus concentration.
IAA production by rhizobacteria
Luria–Bertani (LB) agar medium supplemented with 0.5 mM tryptophan, sodium dodecyl sulfate, and 1 % glycerol was prepared and plated. The bottom of each plate was divided into 16 squares with a marker. Rhizosphere isolates were grown in LB broth overnight. Using sterile tooth picks, isolates were spotted separately in the divided squares. The spotted plates were overlaid immediately with sterile Whatman No. 1 filter paper disks of the inner diameter size. The cultures covered with filter paper were incubated at 30 °C for 2 days. Following appropriate growth of 2 mm of colony diameter, the filter papers were removed from the plates and treated with Salkowski’s reagent (2 % 0.5 M FeCl3 solution in 35 % perchloric acid) in a Petri dish. The filter paper disks were examined for the appearance pink color, which indicated IAA-producing isolates. The colorimetric method was conducted for quantitative analyses of IAA production by rhizosphere microbes. Minimal salt (MS) medium was used with l-tryptophan (Frankenberger and Poth 1988) for IAA-producing microbes. The ability of inoculant to synthesize IAA in broth of MS medium–tryptophan was measured colorimetrically according to Gordon and Weber (1951). Three-day-old bacterial LB broth (100 µL) was transferred to 10 mL MS broth containing 2 mg mL−1 of l-tryptophan. The cultures were incubated at 30 °C with shaking at 150 rpm. After 2 days, the cultures were centrifuged for 10 min at 13,000×g. One milliliter of the supernatant was mixed with 2 mL of Salkowski’s reagent (0.01 M FeCl3 in 35 % HClO4). The test tube contents were left undisturbed for 30 min for color development. Salkowski’s reagent shows variable color responses based on the IAA amount biosynthesized by rhizosphere microbes. Color also was developed in standard IAA solutions; therefore, a standard curve was applied to calculate IAA production in rhizosphere microbes. Pink color appearance indicated IAA production and absorbance was measured at 530 nm (Fig. 1).
Variable color responses depending on the IAA amount using Salkowski’s reagent biosynthesized by rhizosphere microbes prior to the colorimetric quantification according to Gordon and Weber (1951)
IAA production by rhizofungi
Seventeen different fungal isolates were quantitatively tested to produce indole-3-acetic acid IAA following Brick et al. (1991). Fungi were grown in synthetic Czapek-Dox broth amended with tryptophan (1000 μg mL−1) instead of NaNO3. Fungal isolates were inoculated with a loop full of actively growing mycelium spore suspension in Sabouraud media into 10 mL of Czapek-Dox broth media, incubated at 30 °C, and agitated at 150 rpm. Following 7 days, each culture was centrifuged at 13,000×g for 10 min. Salkowski’s reagent (0.01 M FeCl3 in 35 % HClO4) was used to identify indole derivatives. One milliliter of each fungal culture (10 mL) was mixed with an equal volume of Salkowski’s reagent and incubated in the dark for 30 min. The optical density was measured using a spectrophotometer at 530 nm. A standard curve of prepared IAA concentration was designed to calculate the equivalent IAA concentration produced by each fungal strain in the bioassay media.
Results
To determine efficient PGPR, strains with multiple plant growth promotion activities were determined by isolating a total of 105 bacterial strains and 17 fungal strains from the rhizospheric soil supporting P. ginseng in the vicinity of Kangwon National University, Chuncheon City, South Korea (37°87472N, 127°73417E). These isolates were biochemically characterized and screened in vitro for plant growth-promoting features to elicit IAA and calcium phosphate solubilization.
Phosphate-solubilizing activity
Azotobacter chroococcum, P. putida, and E. coli isolates collected from P. ginseng rhizosphere showed 100 % capability to solubilize calcium phosphate (Table 1). This result was followed by P. fluorescens which revealed 77 % capability for inorganic phosphate solubilization. Lactobacillus sp. and Rhodobacter sp. rhizosphere isolates showed 70 and 66 % capacity to solubilize phosphate on Pikovskaya’s agar, respectively. Staphylococcus sp., Bacillus sp., and P. aeruginosa isolates solubilized inorganic calcium phosphate at 60, 50, and 42 %, respectively. Rhizobacteria action on precipitated calcium phosphate agar determined positive phosphate solubilization strains (Fig. 2). Generally, the percentage of rhizobacteria isolates exhibiting phosphate solubilization activity was 57.1 % (Table 1). However, results indicated an overall 82 % phosphate solubilization activity in rhizofungi isolates (Table 2). Aspergillus sp., Penicillium sp., and Trichoderma sp. were common species isolated from P. ginseng rhizosphere plants. Mucor sp., Saccharomyces sp., and Trichoderma sp. isolates all showed 100 % inorganic phosphate solubilization capacity. Aspergillus niger and Penicillium sp. isolates exhibited 75 and 60 % calcium phosphate solubilization capacity, respectively (Table 2). Azotobacter chroococcum and Lactobacillus sp. showed high qualitative and quantitative capacity to solubilize inorganic calcium phosphate. The highest phosphate solubilization efficacy was demonstrated in P. fluorescence and A. chroococcum (Fig. 3). Penicillium sp. showed the maximum phosphate solubilization levels of 316.1 μg mL−1 followed by Mucor sp. (237.3 μg mL−1) on Pikovskaya’s agar (Fig. 4).
IAA production activity
All isolates of A. chroococcum produced the phytohormone IAA (100 %), followed by P. aeruginosa in which 68 % of its isolates were able to produce IAA. P. fluorescens and P. putida isolates exhibited 66 % IAA production. However, both Lactobacillus sp. and Rhodopseudomonas sp. isolates produced only 50 % IAA on LB agar tryptophan medium. Results indicated that the isolates Arthrobacter sp., Listeria sp., and P. plecoglossicida were not able to synthesize the phytohormone IAA. Overall, 50 out of 105 rhizobacterial strains showed IAA productivity in vitro with a percentage value of 47.62 (Table 1). Aspergillus sp. and Mucor sp. rhizosphere exhibited 100 % IAA production in Czapek-Dox broth fortified by tryptophan (1000 μg mL−1). Saccharomyces sp. and Trichoderma sp. strains isolated from P. ginseng rhizosphere showed the capacity to produce IAA of 60 and 50 %, respectively. However, Penicillium sp. isolates showed only a 40 % capacity to produce IAA under the same conditions. Overall, 11 of 17 rhizosphere fungal isolates (64.7 %) produced IAA in Czapek-Dox tryptophan (Table 2). The highest IAA productivity was detected in A. chroococcum, Burkholderia sp., P. putida, Rhodobacter sp., and Streptomyces sp. at a level of 47 μg mL−1. These results were followed by E. coli, Lactobacillus sp., P. aeruginosa, P. fluorescens, and Staphylococcus sp., which produced IAA of 29.7, 23.5, 31.0, 37.2, and 34.1 μg mL−1 in LB tryptophan medium broth, respectively (Table 3). The lowest IAA production value was found in B. subtilis, which produced only 0.2 μg mL−1. A. niger and Saccharomyces sp. showed the highest IAA productivity at the levels of 47 μg mL−1 in Czapek-Dox medium fortified with tryptophan, followed by Mucor sp., which produced 42.3 μg mL−1 of IAA in the same medium. Low IAA productivity of 0.2 and 1.9 μg mL−1 was detected in A. terreus and Trichoderma sp., respectively. IAA production in Penicillium sp. ranged from 2 to 4.5 μg mL−1 (Table 4). Three P. fluorescens, two Rhodobacter sp., two Burkholderia sp., two P. putida, and one A. chroococcum isolates showed high levels of IAA (47 μg mL−1) production in 2 mg mL−1 of tryptophan. P. fluorescens showed strong phosphate solubilization and IAA production of 885.4 and 47.02 μg mL−1, respectively, followed by A. chroococcum with phosphate solubilization and IAA production values of 863.42 and 46.68 μg mL−1, respectively.
Discussion
Plant health and soil fertility are highly dependent on plant–bacterial interactions. Rhizobacteria are capable of increasing plant growth by colonizing plant roots. PGPR are also termed plant health-promoting rhizobacteria and also interact with plants as nodule-promoting rhizobacteria. Plant growth stimulation by rhizobacteria has been demonstrated in both laboratory and field trials. Strains of P. putida and P. fluorescens have enhanced root and shoot length in canola, lettuce, and tomato (Hall et al. 1996; Glick et al. 1997). Phosphorus in insoluble compounds is unavailable to plants, and many rhizobacteria and rhizofungi are capable of solubilizing insoluble phosphates, mostly by secreting chelating organic acids (Richardson 2001; Vessey et al. 2004). It was found that not only plants but also microorganisms including bacteria and fungi are able to synthesize IAA (Kevin 2003; Hontzeas et al. 2004). Actually, IAA introduced by rhizobacteria affects plant metabolic processes because the endogenous pool of plant IAA may be modulated by the interference of IAA that has been secreted by soil bacteria (Glick 2012). Consequently, IAA acts as a mutual signaling molecule interfering gene expression in many rhizobacteria. Therefore, IAA plays a very important role in microbe–plant interactions (Spaepen et al. 2007).
In the present study, more than one hundred rhizobacteria isolates and 17 fungal rhizosphere strains were isolated from P. ginseng plants, a wildly cultivated and economically important species in South Korea, where the climate and soil produce the world’s finest perennial herb in the Araliaceae. The isolated microbial strains showed high variability to biosolubilize the phytohormone IAA and inorganic calcium phosphate, among either fungal or bacterial isolates in defined culture media. The primary objective of this study was to evaluate phytohormone biosynthesis and phosphate solubilization by rhizospherical bacterial and fungal species isolated from the Korean economic crop P. ginseng. Therefore, the strains/species that exhibited the highest activities were selected for quantitative evaluation. In the present investigation, rhizobacterial isolates demonstrated higher IAA productivity and inorganic calcium phosphate solubilization relative to rhizofungal isolates. Alam et al. (2002) demonstrated that bacteria were more efficient in phosphorus solubilization than fungi, consistent with our results. According to our results, the A. chroococcum strain we examined showed distinctive activity in terms of phosphate solubilization and IAA production. A. chroococcum isolates also showed 100 % IAA production capacity, followed by P. aeruginosa, where results showed that 68 % of the isolates produced IAA. P. fluorescens and P. putida isolates showed 66 % IAA production. IAA is one of the most common and well-characterized phytohormones. Patten and Glick (1996) estimated that 80 % of all rhizosphere bacteria produce the phytohormone. However, our results showed that only 50 out of 105 rhizosphere bacterial isolates exhibited IAA production with an overall 47.62 % (Table 3). PGPR mechanisms that promote plant growth are not yet fully understood; however, many different traits of these bacteria are well known for growth promotion activities (Cattelan et al. 1999). Among these mechanisms are plant hormones, including IAA, gibberellic acid, production of siderophores, dissolved phosphates, and other nutrients. Azotobacter fixes dinitrogen and therefore promotes plant growth. The use of phosphate-solubilizing bacteria was reported to increase plant growth, but only in some cases. Therefore, other mechanisms might be involved in growth response (De Freitas et al. 1997). The rhizosphere population and phosphate-solubilizing bacteria depend on the soil physical–chemical properties, (e.g., organic matter and phosphate content) as well as agricultural activities which occur on a farm (Kim et al. 1998). Our results indicated that Arthrobacter sp., Listeria sp., and P. plecoglossicida isolates did not show IAA production. The overall rhizobacteria isolates showed IAA productivity in 50 out of 105 rhizosphere bacterial isolates in 47.62 % (Table 3). In addition, Rodríguez et al. (1996) reported that a strain of B. cepacia did not exhibit IAA production, but displayed a significant mineral phosphate solubilization, and moderate phosphatase activity improved tomato growth. Our results showed phosphate solubilization activity in Brevibacterium sp. and Burkholderia sp. Bacillus sp., Staphylococcus sp., and Streptomyces sp. strains exhibited moderate activity in phosphate solubilization and IAA productivity. Phosphate-solubilizing bacteria have the potential to increase available plant phosphate levels, especially in soils with large amounts of precipitated phosphate (Goldstein 1986). These bacteria solubilize phosphate by secreting organic acids; however, it is not the only way in which phosphate is solubilized (De Freitas et al. 1997; Kim et al. 1998). Phosphate is an important plant nutrient, which is involved in cell division, photosynthesis, energy generation, and nutrient uptake. Phosphate-solubilizing microbes enable phosphate to be available for plant absorption after solubilization. Several soil bacteria, particularly those belonging to the genera Pseudomonas and Bacillus, and fungi belonging to the genera Penicillium and Aspergillus possess the capacity to convert insoluble soil phosphates into available forms by secreting acids, including formic, acetic, propionic, lactic, and glycolic. These acids lower the pH and elicit the dissolution of bound forms of phosphate (Tomar et al. 1998). According to our data, Penicillium sp. showed the highest phosphate solubilization level followed by Mucor sp. on Pikovskaya’s agar (Fig. 4). Among soil bacterial communities, ectorhizospheric strains from Pseudomonads and Bacilli have been described as effective phosphate solubilizers (Igual et al. 2001). The present work demonstrated that 77 % of P. fluorescens were able to solubilize inorganic phosphate. Lactobacillus sp. and Rhodobacter sp. rhizosphere isolates showed 70 and 66 % capacity, respectively, to solubilize phosphate on Pikovskaya’s agar. Staphylococcus sp., Bacillus sp., and P. aeruginosa isolates solubilized inorganic calcium phosphate at 60, 50, and 42 %, respectively. Strains from the genera Pseudomonas, Bacillus, Rhizobium, Burkholderia, Agrobacterium, Micrococcus, and Erwinia had the capacity to solubilize insoluble inorganic phosphate compounds, such as tricalcium phosphate and rock phosphate (Rodríguez et al. 1996; Rodriguez and Fraga 1999).
References
Alam SS, Khalil NA, Rashid M (2002) In vitro solubilization of inorganic phosphate by phosphate solubilizing microorganisms (PSM) from maize rhizosphere. Int J Agric Biol 4:454–458
Atlas RM (2004) Handbook of microbiological media. CRC Press, Boca Raton
Brick JM, Bostock RM, Silversone SE (1991) Rapid in situ assay for indole acetic acid production by bacteria immobilized on nitrocellulose membrane. Appl Environ Microb 57:535–538
Cattelan AJ, Hartel PG, Fuhrmann JJ (1999) Screening for plant growth promoting rhizobacteria to promote early soybean growth. Soil Sci Soc Am J 63:1670–1680
Chen YP, Rekha PD, Arunshen AB, Lai WA, Young CC (2006) Phosphate solubilizing bacteria from subtropical soil and their tricalcium phosphate solubilizing abilities. Appl Soil Ecol 34:33–41
Dave Arti, Patel HH (2003) Impact of different carbon and nitrogen sources on phosphate solubilization by Pseudomonas fluorescens. Indian J Microbiol 43:33–36
De Freitas JR, Banerjee MR, Germida JJ (1997) Phosphate-solubilizing rhizobacteria enhance the growth and yield but not phosphorus uptake of cañóla (Brassica napus L.). Biol Fertil Soils 24:358–364
Domsch KH, Gams W, Anderson T (1980) Compendium of soil fungi, vol 1 and 2. Academic Press, London, pp 405–859
Dutton VM, Evans CS (1996) Oxalate production by fungi: its role in pathogenicity and ecology in the soil environment. Can J Microbiol 42:881–895
Frankenberger WT, Poth M (1988) l-Tryptophan transaminase of a bacterium isolated from the rhizosphere of Festuca octoflora (Graminae). Soil Biol Biochem 20:299–304
Glick BR (2012) Plant growth-promoting bacteria: mechanisms and applications. Hindawi Publishing Corporation, Scientifica
Glick BR, Changping L, Sibdas G, Dumbroff EB (1997) Early development of canola seedlings in the presence of the plant growth-promoting rhizobacterium Pseudomonas putida GR12-2. Soil Biol Biochem 29:1233–1239
Goldstein AH (1986) Bacterial solubilization of mineral phosphates: historical perspectives and future prospects. Am J Altern Agric 1:57–65
Goldstein AH (1994) Involvement of the quinoprotein glucose dehydrogenises in the solubilization of exogenous phosphates by gram-negative bacteria. In: Yagil E, Silver S, Torriani Gorini A (eds) Phosphate in microorganisms: cellular and molecular biology. ASM Press, Washington, DC, pp 197–203
Gordon SA, Weber RP (1951) Colorimetric estimation of indole acetic acid. Plant Physiol 26:192–195
Gürtler V, Stanisich VA (1996) New approaches to typing and identification of bacteria by using the 16S-23S rDNA spacer region. Microbiology 142:3–16
Hall JA, Pierson D, Ghosh S, Glick BR (1996) Root elongation in various agronomic crops by the plant growth promoting rhizobacterium Pseudomonas putida GR12-2. Isr J Plant Sc 44:37–42
Hayat R, Ali S, Amara U, Khalid R, Ahmed I (2010) Soil beneficial bacteria and their role in plant growth promotion: a review. Ann Microbiol 60:579–598
Holt JG (1986) Bergey’s manual of systematic bacteriology. In: Sneath PHA, Mair NS, Sharpe ME, Holt JG (eds) Gram-positive bacteria other than actino-mycetes. Williams & Williams, Baltimore
Hontzeas N, Saleh SS, Glick BR (2004) Changes in gene expression in canola roots by ACC deaminase-containing plant growth-promoting bacteria. Mol Plant Microbe Interact 17:865–871
Husen E (2003) Screening of soil bacteria for plant growth promotion activities in vitro. Indones J Agric Sci 4:27–31
Igual JM, Valverde A, Cervantes E, Velázquez E (2001) Phosphate-solubilizing bacteria as inoculants for agriculture: use of updated molecular techniques in their study. Agronomie 21:561–568
Kevin VJ (2003) Plant growth promoting rhizobacteria as biofertilizers. Plant Soil 255:571–585
Khan MS, Zaidi A, Ahmad E (2014) Mechanism of Phosphate Solubilization and Physiological Functions of Phosphate-Solubilizing Microorganisms. In: Khan MS, Zaidi A, Aamil M (eds) Phosphate Solubilizing Microorganisms. doi:10.1007/978-3-319-08216-5_2. © Springer International Publishing Switzerland 2014
Kim KY, Jordan D, Donald GAM (1998) Effect of phosphate-solubilizing bacteria and vesicular–arbuscular mycorrhizae on tomato growth and soil microbial activity. Biol Fertil Soils 26:79–87
Kloepper JW, Lifshitz R, Zablotowicz RM (1989) Free-living bacterial inocula for enhancing crop productivity. Trends Biotechnol 7:39–43
Kloepper JWE, Young S, Lifshitz R, Zablotowicz RM (1990) Description of a coryneyform plant growth promoting rhizobacteria (PGPR) strain and its effects on plant development. In: Klement AZ (ed) Plant pathogenic bacteria. Akademia, Kiado, pp 613–618
Moubasher AH (1993) Soil fungi in Qatar and other Arab countries. The Centre of Scientific and Applied Research, University of Qater, Doha, Qater
Patten C, Glick BR (1996) Bacterial biosynthesis of indole-3-acetic acid. Can J Microbiol 42:207–220
Pikovskaya RI (1948) Mobilization of phosphorus in soil connection with the vital activity of some microbial species. Microbiologiya 17:362–370
Ponmurugan P, Gopi C (2006) In vitro production of growth regulators and phosphate activity by phosphate solubilizing bacteria. Afr J Biotechnol 5:348–350
Pradhan N, Sukla LB (2005) Solubilization of inorganic phosphate by fungi isolated from agriculture soil. Afr J Biotechnol 5:850–854
Reyes I, Bernier L, Antoun H (2002) Rock phosphate solubilization and colonization of maize rhizosphere by wild and genetically modified strains of Penicillium rugulosum. Microb Ecol 44:39–48
Richardson AE (2001) Prospects for using soil micro-organisms to improve the acquisition of phosphorus by plants. Aust J Plant Physiol 28:897–906
Rodriguez H, Fraga R (1999) Phosphate solubilizing bacteria and their role in plant growth promotion. Biotechnol Adv 17:319–339
Rodríguez H, Goire I, Rodríguez M (1996) Caracterización de cepas de Pseudomonas solubilizadoras de fósforo. Rev ICIDCA 30:47–54
Sagoe CI, Ando T, Kouno K, Nagaoka T (1998) Relative importance of protons and solution calcium concentration in phosphate rock dissolution by organic acids. Soil Sci Plant Nutr 44:617–625
Seshadri S, Ignacimuthu S, Lakshminarsimhan C (2002) Variations in heterotrophic and phosphate solubilizing bacteria from Chennai, southeast coast of India. Indian J Mar Sci 31:69–72
Sharma K, Dak G, Agrawal A, Bhatnagar M, Sharma R (2007) Effect of phosphate solubilizing bacteria on the germination of Cicer arietinum seeds and seedling growth. J Herb Med Toxicol 1:61–63
Spaepen S, Vanderleyden J, Remans R (2007) Indole-3-acetic acid in microbial and microorganism- plant signaling. FEMS Microbiol Rev 31:1–24
Surange S, Wollum AG, Kumar N, Nautiyal CS (1995) Characterization of Rhizobium from root nodules of leguminous trees growing in alkaline soils. Can J Microbiol 43:891–894
Tomar US, Tomar IS, Badaya AK (1998) Response of chemical and biofertilizer on some matric traits in wheat. Crop Res Inst Hissar New Delhi 16:408–410
Turan M, Ataoglu N, Sahin F (2006) Evaluation of the capacity of phosphate solubilizing bacteria and fungi on different forms of phosphorus in liquid culture. J Sustain Agric 28:99–108
Vessey JK, Pawlowski K, Bergman B (2004) Root-based N2-fixing symbioses: legumes, actinorhizal plants, Parasponia sp. and cycads. Plant Soil 266:205–230
Whitelaw MA (2000) Growth promotion of plants inoculated with phosphate solubilizing fungi. Adv Agron 69:99–151
Xie H, Pasternak JJ, Glick BR (1996) Isolation and characterization of mutants of the plant growth-promoting rhizobacterium Pseudomonas putida GR12-2 that overproduce indoleacetic acid. Curr Microbiol 32:67–71
Yazdani M, Bahmanyar MA, Pirdashti H, Esmaili MA (2009) Effect of phosphate solubilization microorganisms (PSM) and plant growth promoting rhizobacteria (PGPR) on yield and yield components of Corn (Zea mays L.). Proc World Acad Sci Eng Technol 37:90–92
Acknowledgments
This study was supported by the National Research Foundation of Korean Government (Project Number: NRF-2013R1A1A2011950).
Author information
Authors and Affiliations
Corresponding author
Rights and permissions
About this article
Cite this article
Hussein, K.A., Joo, J.H. Isolation and characterization of rhizomicrobial isolates for phosphate solubilization and indole acetic acid production. J Korean Soc Appl Biol Chem 58, 847–855 (2015). https://doi.org/10.1007/s13765-015-0114-y
Received:
Accepted:
Published:
Issue Date:
DOI: https://doi.org/10.1007/s13765-015-0114-y